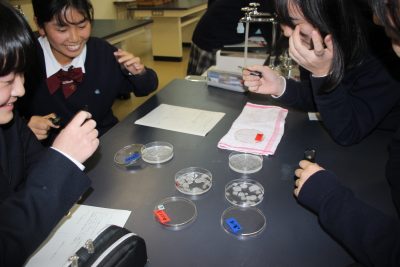

中学1年 理科Ⅱ「深成岩と火成岩」~顕微鏡の神様、生徒に負ける~
2025年11月29日 News
中学1年生は「火成岩」を学びました。火成岩にはマグマが急激に冷えてできた「火山岩」とゆっくり冷えてできた「深成岩」があります。その作りをミョウバンで再現し、顕微鏡で観察しました。ワイワイ、キャーキャーといつもにぎやかに実験をする1年生ですが、提出させた画像を見ますと“ヤバイ”です。きっと老眼がさらに進んだ私よりもクリアな世界がみんなには見えているのでしょう。生徒たち、顕微鏡観察が本当に上手です。神様、完敗。